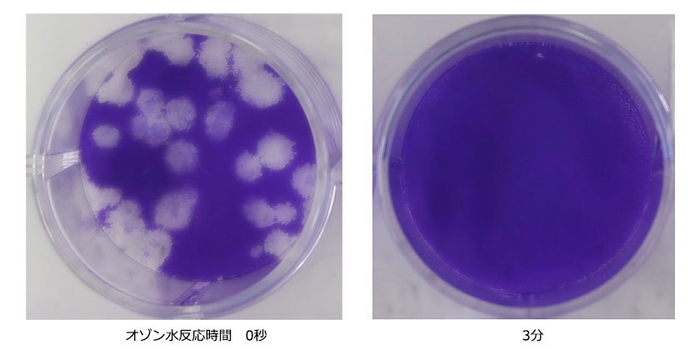
シャーレーでの試験の様子

オゾン水ミストによる、 新型コロナウイルス(SARS-CoV-2)の不活化を実証
美と健康の総合メーカー、株式会社フジ医療器(本社:大阪府大阪市)は、公立大学法人奈良県立医科大学(MBT研究所、微生物感染症学講座 矢野 寿一教授、中野 竜一准教授)及び一般社団法人MBTコンソーシアム(細井 裕司理事長)協力のもと、電気分解法により生成したオゾン水ミストが新型コロナウイルスの不活化※に効果があることを確認しました。
※不活化:感染力を失わせること
試験方法
新型コロナウイルス液をシャーレーに塗抹し、オゾン水ミストを2回噴霧をして、15秒、60秒、3分の反応後、チオ硫酸ナトリウム混合回収液で反応を停止後、ウイルス感染価をプラーク法で測定した。(各工程2回ずつ実施)
試験結果
初期値1.69×10⁶ PFU/ml から、15秒後に1.15×10⁴ PFU/ml(減少率99.10%)、60秒後に1.75×10³ PFU/ml(減少率99.84%)、3分後には1.25×10² PFU/ml(減少率99.99%以上)と検出限界以下まで感染価が減少、不活化した。
減少率は対数減少値より次の通り算出した。(小数点第3位四捨五入)
減少率=(1-1/10対数減少値)×100%
まとめ
本試験は、製品の使用方法に沿った試験条件で行っており、本試験液による拭き取り清掃を行うことで、物質の表面についた新型コロナウイルスによる接触感染防止に有効である可能性が考えられた。

シャーレーでの試験の様子
※色のない斑点部分が新型コロナウイルスが細胞に感染した箇所

フジ医療器 会社概要
社名 : 株式会社フジ医療器
創業 : 1954年
設立 : 1965年4月
代表取締役会長 兼 CEO: 安永 誠司
取締役社長 兼 COO : 大槻 利幸
本社所在地 : 大阪市中央区農人橋1丁目1番22号 大江ビル14階
事業内容 : 健康・美容機器の製造、販売、輸出入
資本金 : 3,000万円
ジョンソンヘルステック(台湾上場)グループ:60%
アサヒホールディングス(東証一部上場)グループ:40%
従業員数 : 752名(2020年3月現在)
URL : https://www.fujiiryoki.co.jp/
フジ医療器お問い合わせ先
フジ医療器お客様相談窓口
【フリーダイヤル】0120-027-612
公立大学法人奈良県立医科大学(橿原市)
昭和20年4月創立、平成19年4月地方独立行政法人化
(学生数1,020名、理事長・学長 細井 裕司)
一般社団法人MBTコンソーシアム(橿原市)
平成28年4月設立、奈良県立医科大学とともにMBT活動に取り組む
(会員企業等104社、理事長 細井 裕司)